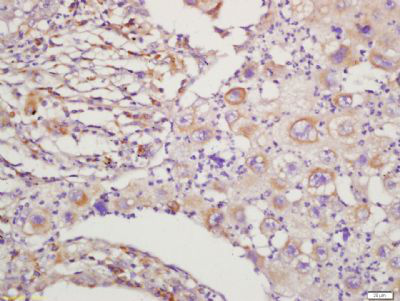

产品货号 : mlR6154
英文名称 : RAC1+RAC2
中文名称 : GTP结合蛋白RAC1+RAC2抗体
别 名 : RAC2_HUMAN; Ras-related C3 botulinum toxin substrate 2; GX; Small G protein; p21-Rac2; EN-7; Gx; HSPC022; RAC1_HUMAN; Ras-related C3 botulinum toxin substrate 1; Cell migration-inducing gene 5 protein; Ras-like protein TC25; p21-Rac1; MIG5; Rac-1; TC-25.
研究领域 : 肿瘤 细胞生物 信号转导 细胞凋亡 细胞粘附分子 G蛋白偶联受体
抗体来源 : Rabbit
克隆类型 : Polyclonal
交叉反应 : Human, Mouse, Rat, Chicken, Dog, Pig, Cow, Horse, Rabbit, Sheep, Guinea Pig,
产品应用 : ELISA=1:500-1000 IHC-P=1:400-800 IHC-F=1:400-800 IF=1:100-500 (石蜡切片需做抗原修复)
not yet tested in other applications.
optimal dilutions/concentrations should be determined by the end user.
分 子 量 : 21kDa
细胞定位 : 细胞浆 细胞膜
性 状 : Lyophilized or Liquid
浓 度 : 1mg/ml
免 疫 原 : KLH conjugated synthetic peptide derived from human RAC1/RAC2.:101-192/192
亚 型 : IgG
纯化方法 : affinity purified by Protein A
储 存 液 : 0.01M TBS(pH7.4) with 1% BSA, 0.03% Proclin300 and 50% Glycerol.
保存条件 : Store at -20 °C for one year. Avoid repeated freeze/thaw cycles. The lyophilized antibody is stable at room temperature for at least one month and for greater than a year when kept at -20°C. When reconstituted in sterile pH 7.4 0.01M PBS or diluent of antibody the antibody is stable for at least two weeks at 2-4 °C.
PubMed : PubMed
产品介绍 : The protein encoded by this gene is a GTPase which belongs to the RAS superfamily of small GTP-binding proteins. Members of this superfamily appear to regulate a diverse array of cellular events, including the control of cell growth, cytoskeletal reorganization, and the activation of protein kinases. Two transcript variants encoding different isoforms have been found for this gene. [provided by RefSeq, Mar 2009].
Function:
Plasma membrane-associated small GTPase which cycles between active GTP-bound and inactive GDP-bound states. In its active state, binds to a variety of effector proteins to regulate cellular responses such as secretory processes, phagocytosis of apoptotic cells, epithelial cell polarization and growth-factor induced formation of membrane ruffles. Rac1 p21/rho GDI heterodimer is the active component of the cytosolic factor sigma 1, which is involved in stimulation of the NADPH oxidase activity in macrophages (By similarity). Essential for the SPATA13-mediated regulation of cell migration and adhesion assembly and disassembly. Isoform B has an accelerated GEF-independent GDP/GTP exchange and an impaired GTP hydrolysis, which is restored partially by GTPase-activating proteins. It is able to bind to the GTPase-binding domain of PAK but not full-length PAK in a GTP-dependent manner, suggesting that the insertion does not completely abolish effector interaction.
Subunit:
Interacts (GTP-bound form preferentially) with PKN2 (via the REM repeats); the interaction stimulates autophosphorylation and phosphorylation of PKN2. Interacts with the GEF proteins PREX1, RASGRF2, DOCK1, DOCK2 and DOCK7, which promote the exchange between GDP and GTP, and therefore activate it. Interacts with PARD6A, PARD6B and PARD6G in a GTP-dependent manner. Part of a quaternary complex containing PARD3, some PARD6 protein (PARD6A, PARD6B or PARD6G) and some atypical PKC protein (PRKCI or PRKCZ), which plays a central role in epithelial cell polarization. Found in a trimeric complex composed of DOCK1 and ELMO1, which plays a central role in phagocytosis of apoptotic cells. Interacts with RALBP1 via its effector domain. Interacts with PLXNB1. Probably found in a ternary complex composed of DSCAM, PAK1 and RAC1. Interacts with DSCAM; the interaction requires PAK1. Part of a complex with MAP2K3, MAP3K3, CCM2 and DEF6. Interacts with BAIAP2, BAIAP2L1, CYFIP1/SRA-1 and DEF6. Interacts with Y.pseudotuberculosis YPKA and PLCB2. Interacts with NOXA1. Interacts with ARHGEF2. Interacts with NISCH (By similarity). Interacts with TBC1D2. Interacts with UNKL. Interacts with USP6. Interacts with SPATA13. Interacts with ARHGEF16; mediates activation of RAC1 by EPHA2. Interacts with ITGB4. Interacts with PIP5K1A.
Subcellular Location:
Cell membrane. Melanosome. Inner surface of plasma membrane possibly with attachment requiring prenylation of the C-terminal cysteine. Identified by mass spectrometry in melanosome fractions from stage I to stage IV.
Tissue Specificity:
Isoform B is predominantly identified in skin and epithelial tissues from the intestinal tract. Its expression is elevated in colorectal tumors at various stages of neoplastic progression, as compared to their respective adjacent tissues.
Post-translational modifications:
AMPylation at Tyr-32 and Thr-35 are mediated by bacterial enzymes in case of infection by H.somnus and V.parahaemolyticus, respectively. AMPylation occurs in the effector region and leads to inactivation of the GTPase activity by preventing the interaction with downstream effectors, thereby inhibiting actin assembly in infected cells. It is unclear whether some human enzyme mediates AMPylation; FICD has such ability in vitro but additional experiments remain to be done to confirm results in vivo.
Similarity:
Belongs to the small GTPase superfamily. Rho family.
SWISS:
P63000
Gene ID:
5879
Important Note:
This product as supplied is intended for research use only, not for use in human, therapeutic or diagnostic applications.
产品图片